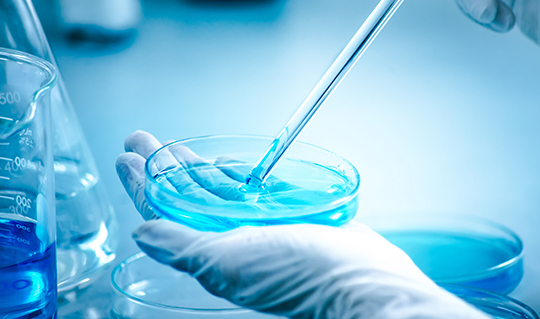

我司構建了含常見、代表性中藥成分2000余種的對照品質譜數據庫,以及覆蓋1500余種藥味、30000余種化合物的理論數據庫,特推出中藥物質基礎 研究相關服務,包括單味藥化學成分分析、中藥復方化學成分分析、中藥體內成分分析、中藥靶向定量分析,詳情請聯系客服。
檢測結果示例如下:

針對高通量常規分析要求,可進行液質方法的優化開發,縮短分析時間,提高分析效能,增加質譜定性的可靠性。在有效的分析窗口內,實現多種化合物的分離分析。
已服務的應用場景:臨床治療藥物檢測;中藥有效成分分析;化學反應中間物質檢測。

1、豐富的生物樣品處理方案,可采用液液萃取,固液萃取多種方法進行樣本中藥物的提取。
2、豐富的樣品分析經驗,針對樣品的理化性質,進行有效的分離分析。
3、穩定的液相質譜檢測平臺,提供符合臨床要求的重現性和穩定性結果。